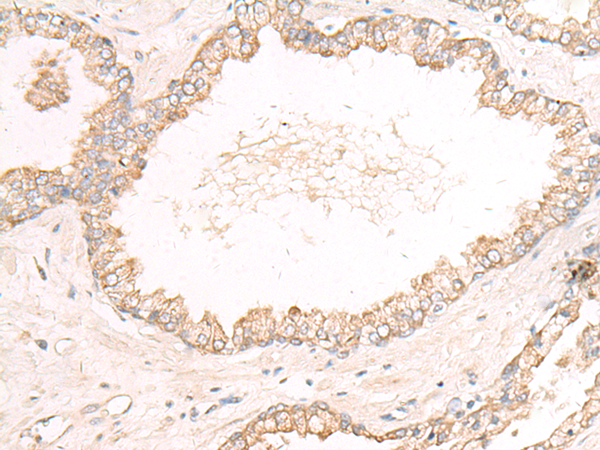

-
分类: 科研抗体货号: P02708别名: LCP; HCLP1; HCLP-1应用: WB,IHC反应种属: Human, Mouse, Rat
-
分类: 科研抗体货号: P02698别名: PPM1O; ILKAP2; ILKAP3; PP2C-DELTA应用: WB,IHC反应种属: Human, Mouse, Rat
-
分类: 科研抗体货号: P02697别名: KIAA0258应用: IHC反应种属: Human, Mouse
-
分类: 科研抗体货号: P02755别名: proRS; MT-PRORS应用: WB,IHC反应种属: Human, Mouse, Rat
-
分类: 科研抗体货号: P02696别名: FPG1; NEI1; hFPG1应用: WB,IHC反应种属: Human
-
分类: 科研抗体货号: P02751别名: PCTK3; PCTAIRE; PCTAIRE3应用: IHC反应种属: Human, Mouse, Rat
-
分类: 科研抗体货号: P02694别名:应用: IHC反应种属: Human, Mouse
-
分类: 科研抗体货号: P02741别名: P43; EFTU; COXPD4; EF-TuMT应用: WB,IHC反应种属: Human, Mouse, Rat
-
分类: 科研抗体货号: P02692别名: DNAJ; HDJ3; LIP6; DRIP78应用: WB,IHC反应种属: Human, Mouse, Rat
-
分类: 科研抗体货号: P02738别名: SQR; SQRDL; CGI-44; PRO1975应用: WB,IHC反应种属: Human, Mouse

鄂公网安备42018502007531号
鄂公网安备42018502007531号

